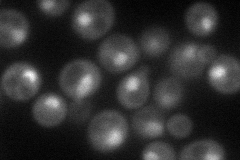
YCL010C
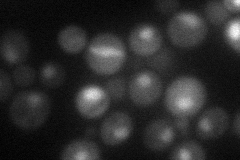
YCL010C
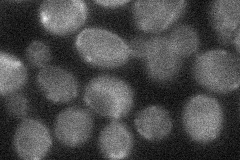
YCL010C
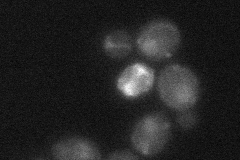
YCL010C

View description
Probable subunit of SAGA histone acetyltransferase complex
Localization:
Intensity:
Fold change:
Significance:
-
C’ GFP library in SD

nucleus38.54 -
N' NOP1pr-GFP in SD
nucleus70.6197 -
N' TEF2pr-mCherry in SD
nucleus34.3771 -
N' NATIVEpr-GFP in SD
cytosol23.8235 -
N' TEF2pr-VC and Cyto-VN in SD
nucleus26.9719 -
C’ GFP library in SD+DTT

nucleus36.130.93No -
C’ GFP library in SD+H2O2

nucleus35.430.91No -
C’ GFP library in Starvation Media

nucleus28.340.73No -
C’ GFP library on the background of Pup2-DaMP

nucleus -
C’ GFP library on the background of CCT mutant

nucleus34.35570.891167No
